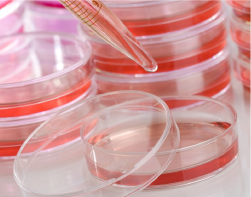

This premium line-up includes Multiwell Plates, T-Flasks, Serological Pipettes, and more!
A must-have for any lab looking for high-quality and affordable cultureware.
Produced with optically clear, high quality, crystalline polymers.
Sterilized by gamma radiation.
Non-pyrogenic.
Cell culture tested.
Designed for reduced cross contamination.
Select products treated for optimal cell attachment and growth.
| Cat # | Description | ||||||||
| SP41117 | 6-well TC Plate, Treated | Yes | 3ml | 9.60 cm2 | Indiv wrap | 1 Case | 50 | $69.92 | $48.94 |
| SP41123 | 12-well TC Plate, Treated | Yes | 2ml | 3.80 cm2 | Indiv wrap | 1 Case | 50 | $69.92 | $48.94 |
| SP41135 | 24-well TC Plate, Treated | Yes | 1ml | 1.90 cm2 | Indiv wrap | 1 Case | 50 | $72.93 | $51.05 |
| SP41207 | 96-well TC Plate, Treated | Yes | 200ul | 0.32 cm2 | Indiv wrap | 1 Case | 50 | $74.72 | $52.30 |
| SP49207 | Strip Immunoplate, 8 well/strip, 85.4x127.6mm | - | 350ul | 0.33 cm2 | 10 pack | 1 Case | 100 | $293.46 | $190.75 |
| Cat # | Description | ||||||||
| SP81136 | T-Flask, 25cm2, Treated with Filter cap - Vented | Yes | 7ml | 25.0 cm2 | 5 pack | 1 Case | 200 | $159.08 | $95.45 |
| SP81186 | T-Flask, 75cm2, Treated with Filter cap - Vented | Yes | 25ml | 75.0 cm2 | 5 pack | 1 Case | 100 | $120.50 | $78.33 |
| SP82286 | T-Flask, 175cm2, Treated with Filter cap - Vented | Yes | 50ml | 175.0 cm2 | 5 pack | 1 Case | 40 | $123.45 | $80.24 |
| Cat # | Description | ||||||||
| SP31146 | Cell Culture Dishes, Treated, 35x10mm | Yes | 3ml | 9.40 cm2 | 10 pack | 1 Case | 500 | $130.53 | $91.37 |
| SP31171 | Cell Culture Dishes, Treated, 60x15mm | Yes | 5ml | 21.5 cm2 | 10 pack | 1 Case | 500 | $152.20 | $98.93 |
| SP31212 | Cell Culture Dishes, Treated, 90x20mm | Yes | 12.5ml | 57.0 cm2 | 10 pack | 1 Case | 200 | $86.79 | $60.75 |
| SP22146 | Cell Culture Dishes, Untreated, 35x10mm | No | 3ml | 9.40 cm2 | 10 pack | 1 Case | 500 | $95.02 | $66.51 |
| SP22171 | Cell Culture Dishes, Untreated, 60x15mm | No | 5ml | 21.5 cm2 | 10 pack | 1 Case | 500 | $115.73 | $81.01 |
| SP22201 | Cell Culture Dishes, Untreated, 90x15mm | No | 12.5ml | 57.5 cm2 | 10 pack | 1 Case | 500 | $125.65 | $87.96 |
| SP22260 | Cell Culture Dishes, Untreated, 150x20mm | No | 35ml | 148.0 cm2 | 10 pack | 1 Case | 120 | $125.09 | $87.56 |
| SP22261 | Cell Culture Dishes, Untreated, 150x25mm | No | 35ml | 148.0 cm2 | 10 pack | 1 Case | 120 | $150.11 | $97.57 |
| Cat # | Description | ||||||||
| CR4111 | Serological Pipette, 1ml stripette | - | 1ml | - | Indiv wrap | 1 Case | 500 | $70.44 | $45.79 |
| CR4112 | Serological Pipette, 2ml stripette | - | 2ml | - | Indiv wrap | 1 Case | 500 | $87.12 | $56.63 |
| SP102116 | Serological Pipette, 5ml stripette | - | 5ml | - | Indiv wrap | 1 Case | 400 | $95.13 | $76.10 |
| SP102121 | Serological Pipette, 10ml stripette | - | 10ml | - | Indiv wrap | 1 Case | 400 | $104.22 | $78.17 |
| SP102136 | Serological Pipette, 25ml stripette | - | 25ml | - | Indiv wrap | 1 Case | 200 | $78.43 | $66.67 |
| SP102161 | Serological Pipette, 25ml stripette | - | 50ml | - | Indiv wrap | 1 Case | 160 | $226.67 | $170.00 |
| Cat # | Description | ||||||||
| SP33161 | Reservoir, 50ml, 1 Channel | - | 50ml | - | Indiv wrap | 1 Case | 50 | $40.99 | $24.59 |
| SP32113 | Reservoir, 25ml, 2 Channel | - | 25ml | - | Indiv wrap | 1 Case | 50 | $42.65 | $25.59 |
| SP32119 | Reservoir, 7ml, 8 Channel | - | 7ml | - | Indiv wrap | 1 Case | 100 | $113.89 | $68.34 |
| SP32123 | Reservoir, 4ml, 12 Channel | - | 4ml | - | Indiv wrap | 1 Case | 100 | $117.57 | $64.66 |
| Cat # | Description | ||||||||
| SP104151 | Cell strainer, 40um Nylon mesh pores | - | - | - | Indiv wrap | 1 Case | 50 | $88.68 | $48.77 |
| SP104181 | Cell strainer, 70um Nylon mesh pores | - | - | - | Indiv wrap | 1 Case | 50 | $84.94 | $46.71 |
| SP104211 | Cell strainer, 100um Nylon mesh pores | - | - | - | Indiv wrap | 1 Case | 50 | $92.48 | $50.87 |
| Cat # | Description | ||||||||
| SP61126 | Conical Centrifuge Tube, 15ml, RCF 5500 | - | 15ml | - | 50 pack | 1 Case | 500 | $106.96 | $69.52 |
| SP91141 | Cell Scraper, 100 per case, 2cmx30cm | - | - | - | Indiv wrap | 1 Case | 100 | $65.63 | $39.38 |
| SP91151 | Cell Lifter, 23mm & 12mm (Double Blade) | - | - | - | Indiv wrap | 1 Case | 100 | $48.68 | $29.21 |
Terms and Conditions: Offer valid through December 31, 2020. Valid for a minimum order size of $150 per order. Valid only for customers in North America. Cannot be combined with any other promotion. Shipping extra. Valid only for items listed on this page in the indicated formats. Orders must be placed directly through Bio Basic or a qualifying Biobar. Orders placed through stores or distributors are not eligible to receive this offer.
order@biobasic.com
1 (905) 474‐4493
1 (800) 313‐7224
1 (905) 474‐5794